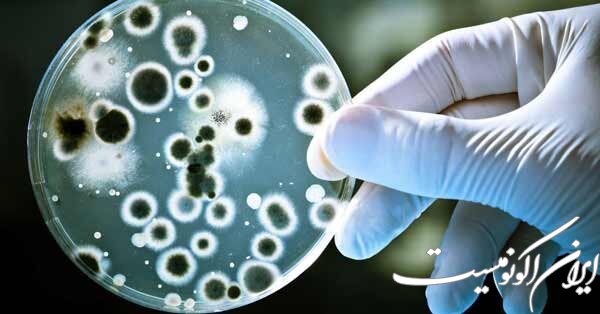

به گزارش باشگاه دانشجویان ایران اکونومیست، این کارگاه نخستین برنامه از سری صفر تا صد بخش میکروبشناسی عملی آزمایشگاه تشخیص طبی است که ۲۳ و ۲۴ شهریور ماه ساعت ۱۶:۳۰ الی ۲۰، با تدریس دکتر علی احمدی ـ مدرس کارگاههای تخصصی علوم آزمایشگاهی، بهصورت آنلاین در بستر اسکای روم برگزار میشود.
«بررسی کامل انواع رنگآمیزی، شناسایی میکروسکوپی و مورفولوژی باکتریها»، «معرفی و بررسی انواع محیطهای کشت و روشهای کشت»، «معرفی و تفسیر دیسکها و تستهای شناسایی» و «تفسیر کامل چارتهای تشخیصی و نتایج بهدست آمده» از مباحث و سرفصلهای آموزشی این دوره است.
علاقهمندان میتوانند جهت ثبتنام به شناسه Workshop_Ad@ پیام ارسال کنند.